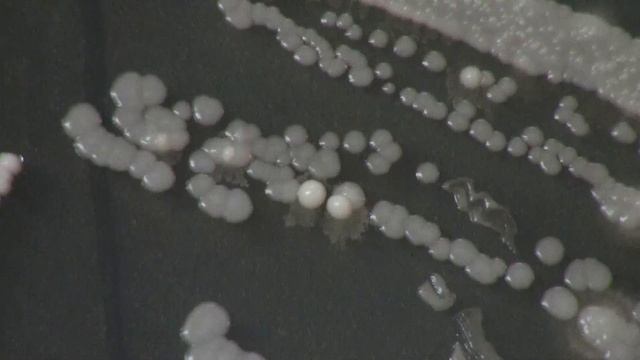
Capturing Wild Yeast Part III - Identifying Usable Yeasts смотреть онлайн

Автор / Канал: Грибные канцелярские принадлежности Страница 2

My BEpic Elev8 Review

Сосны в парке 28 , Алматы

Playing Crossout LIVE

Warningfog - Ophiocordyceps

Молодость в 55 +😆

Marine Material & Biological Research Group

Me and Mr.President

Мотор Депот в ожидании обновления.

Шпыг Яна

11 1 J+J 2021

Dile ADIÓS a las BACTERIAS Y HONGOS con ¡PENTAHCU!

«Как быть больным и путникам, которые желают поститься в Рамазане?»

სამმაგი სარგებელი - მდიდარი მოსავლისთვის.მიკორიზას სოკო ვერაგი სარეველასგან

#shorts Chocolate Donut Brownies | Sweet Dish| Chocolate Lover| Dark Chocolate| Chocolate ganache |

Пародия Тает лёд!!! SAMP

«Диво» 14.07.23

Hockey Chance-3 - ДжейДжей | 10.07.21

МБОУ ШОВЗ «Широкая Масленица-2024»

Багавд Гита гл 4 текст 16
Capturing Wild Yeast Part III - Identifying Usable Yeasts

Мухоморы сушёных на костре. #РОМОХУМ #здоровье #здоровье #мухоморы #ZVUKISHU

Грибники 90 lvl...😂😂😂

✅ЗАКУСКА ИЗ БАКЛАЖАН

Texas Bushcraft: The Island Update/ Texas Tinder Fungus
За каждым успешным каналом стоит личность, идея и сотни часов кропотливого труда. Если вы здесь, значит, автор «Грибные канцелярские принадлежности» уже сумел зацепить ваше внимание своим уникальным стилем или подачей. А мы на RUVIDEO позаботились о том, чтобы вы могли изучить весь архив его работ в максимально комфортных условиях — без лишней суеты и преград.
Почему за работами канала «Грибные канцелярские принадлежности» так интересно наблюдать? Всё просто: это честный контент, который находит отклик в сердцах зрителей. На нашем ресурсе вы можете смотреть онлайн все видео любимого автора бесплатно и в хорошем качестве. Нам важно, чтобы вы видели каждую деталь и слышали каждый нюанс, поэтому мы используем только стабильные плееры из открытых источников Rutube.
Следите за новинками канала, пересматривайте старые шедевры и открывайте для себя новые грани творчества «Грибные канцелярские принадлежности». Мы постоянно обновляем ленту, чтобы у вас под рукой всегда были самые свежие выпуски. Никаких сложных регистраций — только вы и творчество, которое вдохновляет. Приятного вам путешествия по миру авторского контента на RUVIDEO!
Видео взято из открытых источников Rutube. Если вы правообладатель, обратитесь к первоисточнику.